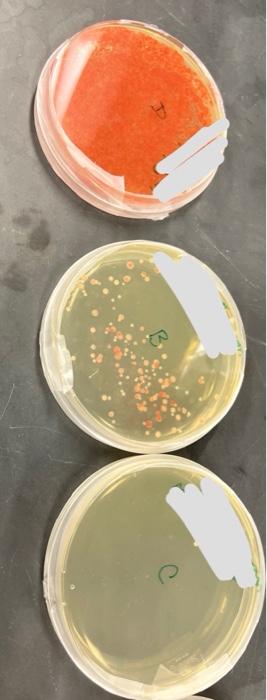
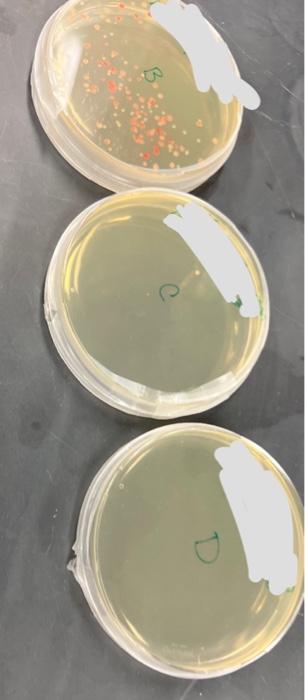

Home /
Expert Answers /
Biology /
here-is-the-experiment-directions-and-results-i-am-mostly-confused-about-which-dishes-go-into-e-col-pa220
(Solved): here is the experiment directions and results. I am mostly confused about which dishes go into E Col ...
here is the experiment directions and results. I am mostly confused about which dishes go into E Coli and which to S marcescens. Which are which, what colors distinguish them? etc. If you could answer 1 a-c thats great!

Spread Plate Method of Isolation OBSERVATIONS AND INTERPRETATIONS 1 Record your observations in the table below. QUESTIONS Think about your results in attempting to isolate E. coli and S. marcescens. a. On which plate did you first obtain isolation with E. coli? b. On which plate did you first obtain isolation with \( \mathrm{S} \). marcescens? c. Do you have reason to suspect that they should become isolated on the same dilution plate? Why or why not?
Spread Plate Method of Isolation ? Theory \( 1.40 \) spread Plete Set-up a The spread plute technique requires a flutien 1.41 Delivering the inoculum = Deposit the inoculum baner, a suew-Cop jar wath akcohol a glass spreading rod, and the plate. Position near one side of the agar surface. Use the lid as a shickd and This amangement secuses the chance of accidentaly catching the alcohol on fre properly dipose of the pipetse or pipetse tp in a sharps of Notice the cotion in the jar's bottom to reduce the chance of breaking the glass fod. SLCTIOW1 Fundamental Shalls for the Microbiology Laboratory
\( 1.43 \) spreading the inoculum = After the fame has gone out on the rod ift the lid of the plate and use it as a shieid from aitoone contamination. Then, touch the rod to the agar surface away from the inoculum in order to cool it To spread the inoculum, hold the plate Id with the base of your thumb and index fingec and use the tip of your \( 1.44 \) spreading with a Tum table an An inoculating tumtable thumb and middle finger to rodete the bame. At the same time move the rod in a backand-forth motion accoss the agar surlace Afier a couple of turns, do one last turn wath the rod next to the phate's edge.
" Hecause this is noc a quastitusive growedare, it a noe becenary bo fame the boop lveterne tranders.
Expert Answer
First achieved isolation on plate 3 for both E. coli and S. marcescens.E.coli Plate 3 Formed individual colonies separate from S. marcescens E. oli are bacteria found in the intestines of people and animals and in the environment; they c